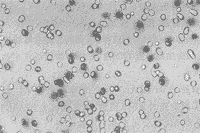

3种干扰因子对人肺癌细胞株A549体外增殖、侵袭力及ICAM-1表达的调节作用
作者:周人杰 肖颖彬 张国强 王志新 周德昌
单位:周人杰 肖颖彬 张国强 周德昌:第三军医大学:附属新桥医院胸外科;王志新:附属新桥医院全军肿瘤治疗中心;重庆 400037
关键词:全反维甲酸;细胞株;体外侵袭力;ICAM-1
第三军医大学学报991210 提要 目的:研究全反维甲酸(ATRA)等干扰因子对肺癌细胞株A549侵袭、增殖及ICAM-1分子表达的调节作用。方法:根据细胞穿过铺有Matrigel胶多孔膜数量检测细胞侵袭力,用改良龙胆紫吸收比色计数法检测细胞增殖,以流式细胞分析和酶联免疫吸附试验检测ICAM-1、sICAM-1表达水平。结果:A549经ATRA处理后,细胞表面ICAM-1表达降低,体外侵袭力明显降低,体外增殖明显抑制;IFN α不增加细胞ICAM-1表达,但抑制体外增殖及体外侵袭力;IL-1明显增强细胞表面ICAM-1表达及培养上清sICAM-1含量,体外侵袭力有增高趋势。结论:ATRA、IFN α、IL-1对A549细胞体外增殖及ICAM-1、sICAM-1表达有不同的调节作用,而对其转移潜能具有不同调变作用。
, 百拇医药
中图法分类号 R734.2;R977.2 文献标识码 A
文章编号:1000-5404(1999)12-0899-03
Regulative effects of three interfering factors on invasiveness, proliferation and expression of intercellular adhesion molecule-1 of human pulmonary carcinoma cell line A549 in vitro
ZHOU Ren-jie, XIAO Ying-bin, ZHANG Guo-qiang, WANG Zhi-xin, ZHOU De-chang
(Department of Oncology, Xinqiao Hospital, Third Military Medical University, Chongqing 400037)
, 百拇医药
Abstract Objective: To investigate the effects of ATRA, IL-1 and IFN α on the invasiveness, proliferation and the expression of intercellular adhesion molecule-1 (ICAM-1) of human pulmonary carcinoma cell line A549 in vitro.Methods: The invasiveness was assessed by penetration through a matrigel-coated filter, the proliferation was determined by the method reported by Gillies and cell surface ICAM-1 and sICAM-1 analyzed by flow cytometry and ELISA.Results: Pretreatment with ATRA and IFN α strong decreased the invasiveness of the cell line.ICAM-1 was strong decreased by ATRA but increased by IL-1.However, IFN α had little or no effects on ICAM-1 expression.SICAM-1 was not found on the A549 cells even after the treatment with ATRA and IFN α.IL-1 significantly increased the sICAM-1 content in the supernatant.Treatment with IFN α and IL-1 had little or no effects on the proliferation of the cells.Conclusion: ATRA can exert inhibitory effects on proliferation, invasiveness and ICAM-1 expression of A549 cells.Comparing with IFN α and IL-1, its effects are more powerful.
, http://www.100md.com
Key words ATRA; lung cancer; invasiveness; proliferation; intercellular adhesion molecule-1
恶性肿瘤的侵袭与转移是受多因素调控的复杂过程,涉及肿瘤细胞恶性增殖、肿瘤组织新生血管形成、肿瘤细胞粘附、分泌蛋白酶降解基质及肿瘤细胞迁移运动等一系列过程。其中介导细胞粘附作用的细胞表面粘附分子的表达及其在肿瘤中的作用,是目前肿瘤研究中的一个热点[1]。ICAM-1高表达的肿瘤细胞易于脱离母体,随淋巴细胞游走,而发生转移[2]。在人类流行病学、动物实验及临床研究均已证实维甲酸(Retinoic acid,RA)类可用于肺癌的化学预防及治疗[3]。我们研究了全反维甲酸(All-trans retinoic acid,ATRA)等干扰因子对肺癌细胞株A549体外增殖、侵袭力及ICAM-1、sICAM-1表达水平的影响,旨在探讨ATRA等干扰因子对肿瘤转移潜能的影响及ICAM-1分子在肿瘤侵袭中的作用。
, http://www.100md.com
1 材料与方法
1.1 细胞及其处理方法
A549细胞用含10%小牛血清的DMEM培养基培养,适时更换培养液及传代,逐渐降低培养液中小牛血清浓度直至无血清培养。细胞分别加入5 μmol/L ATRA、1 000 U/ml IFN α、200 U/ml IL-1(购于北京中山公司)终浓度的培养液,对照组为相应的培养液,37°C孵育24 h,用于实验。
1.2 体外侵袭实验
将200 μlNIH 3T3细胞培养上清液作为趋化物加入Boy-den小室(美国Millipore公司)的下室,上下室之间由直径12 mm、孔径12 μm的多孔聚碳膜分隔,在膜上铺50 μl(50 μg蛋白,DMEM稀释)基质胶Matrigel(北京医科大学提供),胶干后,将不同处理的400 μl(2×105个细胞)分别加入上室。37°C 5% CO2孵育6 h后取出膜,擦去膜上面未穿过的细胞及基质胶,用甲醇固定,HE染色后,在显微镜下将多聚碳膜分成9等格,分别计数9格内的细胞数,取其平均值,即为每格内侵袭的细胞数。每组设2个样本,重复3次。
, 百拇医药
1.3 体外增殖检测
采用Gillies等[4]建立的改良龙胆紫吸收比色计数法。将待计数的细胞接种于24孔细胞培养板中,置37°C 5%CO2孵育7 h,使细胞充分贴壁,以1%戊二醛-Hank's液固定15 min后,以0.1%无离子龙胆紫溶液1 ml染色30 min;将培养板置于1 L的大烧杯中,在其底部以连续缓流的无离子水(0.5 ml/min)脱染15 min,于空气中自然干燥,以0.2% TritonX-100溶液溶解细胞,在室温25°C左右,波长为590 nm分光光度仪上检测光密度(OD)值。以已计数的A549细胞0.75、1.5、3.0、4.5、6.0、7.5、10.0、12.5×104/ml接种于24孔培养板,按上法操作,建立细胞数与光密度关系的标准曲线。以4.0×104/ml细胞接种于24孔培养板中,分别加入5 μmol/L ATRA、1 000 U/ml IFN α、200 U/ml IL-1的培养液,对照为相应培养液,37°C孵育48 h,按上法检测各孔OD值,根据标准曲线求出细胞数,每例设6个复孔。
, http://www.100md.com
1.4 细胞表面ICAM-1表达水平的检测
取不同处理的A549细胞,加入鼠抗人ICAM-1(CD54)单抗(美国ZYMED公司产品),阴性对照以PBS代替一抗,4°C孵育30 min,PBS洗3遍,加入FITC标记的羊抗鼠IgG(购于北京中山公司),4°C孵育30 min,PBS洗3遍后,用FACstar流式细胞仪(Becton Dickinson)检测荧光强度,每个标本测10000个细胞。
1.5 细胞培养上清液sICAM-1含量检测
取不同处理的A549细胞培养上清液,以人sICAM-1 ELISA试剂盒(美国Ancell公司)进行检测,操作步骤按说明书进行。
2 结果
2.1 ATRA等对A549细胞体外增殖能力的影响
, http://www.100md.com
IFN α(1000 U/ml)IL-1(200 U/ml)对A549细胞体外增殖无明显影响(P>0.05),而ATRA(5 μmol/L)处理后,较对照组细胞增殖明显受抑制[(8.11±0.22)×104/ml vs (10.15±0.56)×104/ml,P<0.01]。
2.2 ATRA等对A549细胞ICAM-1、sICAM-1表达水平的影响
A549细胞ICAM-1阳性率为36.5%,经IL-1处理后表达水平明显增强(阳性率63.5%,P<0.05),而经ATRA处理后下降(阳性率28.2%,P<0.05),IFN α处理后无明显变化(阳性率38.1%,P>0.05)。A549细胞培养上清液无法检测出sICAM-1表达(<0.625 ng/ml),经IFN α、ATRA处理后亦不增加sICAM-1 水平(<0.625 ng/ml),但经IL-1处理后,sICAM-1含量明显增高[(3.01±0.75)ng/ml,P<0.05]。
, http://www.100md.com
2.3 ATRA等对A549细胞体外侵袭力的影响
根据细胞穿过Matrigel胶的能力,检测不同处理的A549细胞体外侵袭力的变化。结果显示,IFN α或ATRA处理组细胞侵袭力低于对照组细胞(P<0.05),而IL-1处理组细胞侵袭力与对照组比较,差异不显著(P>0.05),见图1~4。
图1 未经处理的A549细胞体外侵袭力测定
(每格细胞数185.1±28.1 HE×200)
Fig 1 The assesement of the invasiveness of untreated A549 cells in vitro
(185.1±28.1 cells per lattice HE×200)
, 百拇医药
图2 经IL-1(200 U/ml)处理24 h,A549细胞侵袭力有增强趋势,但差异不显著
(每格细胞数272.6±72.3 HE×200)
Fig 2 IL-1 (200 U/ml) treatment for 24 h increased the invasiveness of A549 cells, but no statistical significance
(272.6±72.3 cells per lattice HE×200)
图3 经IFN α(1 000 U/ml)处理24 h,A549细胞侵袭力降低
(每格细胞数111.4±21.1 HE×200)
, http://www.100md.com
Fig 3 IFN α (1 000 U/ml)treatment for 24 h decreased the invasiveness of A549 cells
(111.4±21.1 cells per lattice HE×200)
图4 经ATRA(5 μmol/L)处理24 h,A549侵袭力降低
(每格细胞数101.2±27.9 HE×200)
Fig 4 ATRA (5 μmol/L) treatment for 24 h decreased the invasiveness of A549 cells (101.2±27.9 cells per lattice HE×200)
, http://www.100md.com
3 讨论
全反维甲酸(ATRA)是体内具有重要生理活性的Vit A代谢产物之一,国内外一些报道表明:RA类化合物具有抑制细胞增殖、诱导肿瘤细胞分化及程序性死亡、抗肿瘤血管生成等特性[3]。我们检测了ATRA、IL-1、IFNα处理的A549细胞体外增殖能力,结果显示:ATRA处理的A549细胞体外增殖明显受抑制,而IFN α、IL-1处理细胞体外增殖无明显变化,与其它报道基本一致。
粘附是肿瘤细胞侵袭转移过程中的重要环节。粘附因子介导肿瘤细胞与细胞外基质、血管内皮细胞、靶器官细胞之间的相互作用,因此与肿瘤侵袭转移行为密切相关[1]。ICAM-1是一种细胞粘附分子,Natali等[5]研究发现ICAM-1表达水平与黑色素瘤瘤体厚度及临床病程有很高的相关性,ICAM-1高表达的肿瘤细胞侵袭转移能力高。我们的实验结果显示:ATRA处理A549细胞后,细胞表面ICAM-1下降,而IL-1处理组ICAM-1表达增强,IFN α处理组ICAM-1表达无明显变化。其他学者[6,7]对黑色素瘤、乳腺癌等的研究,亦发现了相似的结果。这一结果显示,由于IFN α、IL-1和ATRA对肿瘤细胞ICAM-1表达的不同作用可能导致肿瘤细胞侵袭转移行为有所不同,IL-1由于上调肿瘤细胞ICAM-1的表达而增加其侵袭转移的潜能,ATRA下调ICAM-1的表达而抑制其侵袭转移潜能。
, http://www.100md.com
近年来,发现了另一类型的ICAM-1分子,即存在于肿瘤宿主血清或细胞培养上清液中的可溶性ICAM-1(sICAM-1)。sICAM-1的存在,可以阻断LFA-1/ICAM-1介导的淋巴细胞对肿瘤细胞识别,从而抑制机体抗肿瘤免疫,促进转移发生[8]。Parhar等[9]认为nm23基因抗转移能力可能是通过降低肿瘤细胞产生sICAM-1来介导的。从实验结果看:IFN α或ATRA处理A549细胞sICAM-1含量不增高,而IL-1处理细胞后,sICAM-1含量明显增高,由此看ATRA处理细胞使ICAM-1表达降低和sICAM-1含量不增高对抑制肿瘤侵袭转移潜能的作用是一致的。因此,ATRA、IFN α、IL-1对A549细胞体外增殖及ICAM-1、sICAM-1表达有不同的调节作用,而对其转移潜能具有不同调变作用。ATRA对肿瘤的化学预防作用可能是通过抑制细胞增殖、调节2种形式ICAM-1表达进而抑制其转移潜能实现的。
(致谢:感谢附属大坪医院野战外科研究所创伤科简华刚副教授及第二研究室江其生博士对本实验提供的大力协助。)
, 百拇医药
作者简介:周人杰,男,1971.04.05生,浙江省慈溪市人,硕士,住院医师,主要从事肺癌方面的研究,发表论文2篇。电话:(023)68755724
参考文献
[1] Lalani E L N, Laniado M E, Abel P D.Molecular and cellular biology of prostate cancer[J].Cancer Metastasis Rev,1997,16(1):29-66.
[2] Natali P G, Nicotra M R, Cavaliere R, et al.Differential expression of intercellular adhesion molecule 1 in primary and metastatic melanoma lesions[J].Cancer Res,1990,50(15):1271-1278.
, http://www.100md.com
[3] 王志洁.维甲酸化学预防肺癌的研究进展[J].国外医学:肿瘤学分册,1998,25(2):106-109.
[4] Gillies R J, Didier N, Denton M.Determination of cell number in monolayer cultures[J].Anal Biochem,1986,159(1):109-113.
[5] Natali P G, Hamby C V, Felding-Habermann B, et al.Clinical significance of α v β3 integrin and intercellular adhesion molecule-1 expression in cutaneous malignant lesions[J].Cancer Res,1997,57(15):1554-1560.
, 百拇医药
[6] 罗利群,张友会,黄兰青,等.干扰素对小鼠乳腺癌细胞侵袭力及转移相关基因表达的调变[J].中华肿瘤杂志,1997,19(3):184-187.
[7] Creyghton W M, de-Waard-Siebinga I, Danen E H, et al.Cytokine-mediated modulation of integrin ICAM-1 and CD44 expression on human uveal melanoma cells in vitro[J].Melanoma Res,1995,5(4):235-242.
[8] Banks R E, Gearing A J H, Hemingway I K, et al.Circulating intercellular adhesion molecule-1(ICAM-1),E-selectin and vascular cell adhesion molecule-1(VCAM-1)in human malignancies[J].Br J Cancer,1993,68(1):122-124.
[9] Parhar R S, Shi Y,Zou M, et al.Effects of cytokine-mediated modulation of nm23 expression on the invasion and metastatic behavior of B16F10 melanoma cells[J].Int J Cancer,1995,60(2):204-210.
收稿日期:1999-05-05;修回日期:1999-08-10, 百拇医药
单位:周人杰 肖颖彬 张国强 周德昌:第三军医大学:附属新桥医院胸外科;王志新:附属新桥医院全军肿瘤治疗中心;重庆 400037
关键词:全反维甲酸;细胞株;体外侵袭力;ICAM-1
第三军医大学学报991210 提要 目的:研究全反维甲酸(ATRA)等干扰因子对肺癌细胞株A549侵袭、增殖及ICAM-1分子表达的调节作用。方法:根据细胞穿过铺有Matrigel胶多孔膜数量检测细胞侵袭力,用改良龙胆紫吸收比色计数法检测细胞增殖,以流式细胞分析和酶联免疫吸附试验检测ICAM-1、sICAM-1表达水平。结果:A549经ATRA处理后,细胞表面ICAM-1表达降低,体外侵袭力明显降低,体外增殖明显抑制;IFN α不增加细胞ICAM-1表达,但抑制体外增殖及体外侵袭力;IL-1明显增强细胞表面ICAM-1表达及培养上清sICAM-1含量,体外侵袭力有增高趋势。结论:ATRA、IFN α、IL-1对A549细胞体外增殖及ICAM-1、sICAM-1表达有不同的调节作用,而对其转移潜能具有不同调变作用。
, 百拇医药
中图法分类号 R734.2;R977.2 文献标识码 A
文章编号:1000-5404(1999)12-0899-03
Regulative effects of three interfering factors on invasiveness, proliferation and expression of intercellular adhesion molecule-1 of human pulmonary carcinoma cell line A549 in vitro
ZHOU Ren-jie, XIAO Ying-bin, ZHANG Guo-qiang, WANG Zhi-xin, ZHOU De-chang
(Department of Oncology, Xinqiao Hospital, Third Military Medical University, Chongqing 400037)
, 百拇医药
Abstract Objective: To investigate the effects of ATRA, IL-1 and IFN α on the invasiveness, proliferation and the expression of intercellular adhesion molecule-1 (ICAM-1) of human pulmonary carcinoma cell line A549 in vitro.Methods: The invasiveness was assessed by penetration through a matrigel-coated filter, the proliferation was determined by the method reported by Gillies and cell surface ICAM-1 and sICAM-1 analyzed by flow cytometry and ELISA.Results: Pretreatment with ATRA and IFN α strong decreased the invasiveness of the cell line.ICAM-1 was strong decreased by ATRA but increased by IL-1.However, IFN α had little or no effects on ICAM-1 expression.SICAM-1 was not found on the A549 cells even after the treatment with ATRA and IFN α.IL-1 significantly increased the sICAM-1 content in the supernatant.Treatment with IFN α and IL-1 had little or no effects on the proliferation of the cells.Conclusion: ATRA can exert inhibitory effects on proliferation, invasiveness and ICAM-1 expression of A549 cells.Comparing with IFN α and IL-1, its effects are more powerful.
, http://www.100md.com
Key words ATRA; lung cancer; invasiveness; proliferation; intercellular adhesion molecule-1
恶性肿瘤的侵袭与转移是受多因素调控的复杂过程,涉及肿瘤细胞恶性增殖、肿瘤组织新生血管形成、肿瘤细胞粘附、分泌蛋白酶降解基质及肿瘤细胞迁移运动等一系列过程。其中介导细胞粘附作用的细胞表面粘附分子的表达及其在肿瘤中的作用,是目前肿瘤研究中的一个热点[1]。ICAM-1高表达的肿瘤细胞易于脱离母体,随淋巴细胞游走,而发生转移[2]。在人类流行病学、动物实验及临床研究均已证实维甲酸(Retinoic acid,RA)类可用于肺癌的化学预防及治疗[3]。我们研究了全反维甲酸(All-trans retinoic acid,ATRA)等干扰因子对肺癌细胞株A549体外增殖、侵袭力及ICAM-1、sICAM-1表达水平的影响,旨在探讨ATRA等干扰因子对肿瘤转移潜能的影响及ICAM-1分子在肿瘤侵袭中的作用。
, http://www.100md.com
1 材料与方法
1.1 细胞及其处理方法
A549细胞用含10%小牛血清的DMEM培养基培养,适时更换培养液及传代,逐渐降低培养液中小牛血清浓度直至无血清培养。细胞分别加入5 μmol/L ATRA、1 000 U/ml IFN α、200 U/ml IL-1(购于北京中山公司)终浓度的培养液,对照组为相应的培养液,37°C孵育24 h,用于实验。
1.2 体外侵袭实验
将200 μlNIH 3T3细胞培养上清液作为趋化物加入Boy-den小室(美国Millipore公司)的下室,上下室之间由直径12 mm、孔径12 μm的多孔聚碳膜分隔,在膜上铺50 μl(50 μg蛋白,DMEM稀释)基质胶Matrigel(北京医科大学提供),胶干后,将不同处理的400 μl(2×105个细胞)分别加入上室。37°C 5% CO2孵育6 h后取出膜,擦去膜上面未穿过的细胞及基质胶,用甲醇固定,HE染色后,在显微镜下将多聚碳膜分成9等格,分别计数9格内的细胞数,取其平均值,即为每格内侵袭的细胞数。每组设2个样本,重复3次。
, 百拇医药
1.3 体外增殖检测
采用Gillies等[4]建立的改良龙胆紫吸收比色计数法。将待计数的细胞接种于24孔细胞培养板中,置37°C 5%CO2孵育7 h,使细胞充分贴壁,以1%戊二醛-Hank's液固定15 min后,以0.1%无离子龙胆紫溶液1 ml染色30 min;将培养板置于1 L的大烧杯中,在其底部以连续缓流的无离子水(0.5 ml/min)脱染15 min,于空气中自然干燥,以0.2% TritonX-100溶液溶解细胞,在室温25°C左右,波长为590 nm分光光度仪上检测光密度(OD)值。以已计数的A549细胞0.75、1.5、3.0、4.5、6.0、7.5、10.0、12.5×104/ml接种于24孔培养板,按上法操作,建立细胞数与光密度关系的标准曲线。以4.0×104/ml细胞接种于24孔培养板中,分别加入5 μmol/L ATRA、1 000 U/ml IFN α、200 U/ml IL-1的培养液,对照为相应培养液,37°C孵育48 h,按上法检测各孔OD值,根据标准曲线求出细胞数,每例设6个复孔。
, http://www.100md.com
1.4 细胞表面ICAM-1表达水平的检测
取不同处理的A549细胞,加入鼠抗人ICAM-1(CD54)单抗(美国ZYMED公司产品),阴性对照以PBS代替一抗,4°C孵育30 min,PBS洗3遍,加入FITC标记的羊抗鼠IgG(购于北京中山公司),4°C孵育30 min,PBS洗3遍后,用FACstar流式细胞仪(Becton Dickinson)检测荧光强度,每个标本测10000个细胞。
1.5 细胞培养上清液sICAM-1含量检测
取不同处理的A549细胞培养上清液,以人sICAM-1 ELISA试剂盒(美国Ancell公司)进行检测,操作步骤按说明书进行。
2 结果
2.1 ATRA等对A549细胞体外增殖能力的影响
, http://www.100md.com
IFN α(1000 U/ml)IL-1(200 U/ml)对A549细胞体外增殖无明显影响(P>0.05),而ATRA(5 μmol/L)处理后,较对照组细胞增殖明显受抑制[(8.11±0.22)×104/ml vs (10.15±0.56)×104/ml,P<0.01]。
2.2 ATRA等对A549细胞ICAM-1、sICAM-1表达水平的影响
A549细胞ICAM-1阳性率为36.5%,经IL-1处理后表达水平明显增强(阳性率63.5%,P<0.05),而经ATRA处理后下降(阳性率28.2%,P<0.05),IFN α处理后无明显变化(阳性率38.1%,P>0.05)。A549细胞培养上清液无法检测出sICAM-1表达(<0.625 ng/ml),经IFN α、ATRA处理后亦不增加sICAM-1 水平(<0.625 ng/ml),但经IL-1处理后,sICAM-1含量明显增高[(3.01±0.75)ng/ml,P<0.05]。
, http://www.100md.com
2.3 ATRA等对A549细胞体外侵袭力的影响
根据细胞穿过Matrigel胶的能力,检测不同处理的A549细胞体外侵袭力的变化。结果显示,IFN α或ATRA处理组细胞侵袭力低于对照组细胞(P<0.05),而IL-1处理组细胞侵袭力与对照组比较,差异不显著(P>0.05),见图1~4。
图1 未经处理的A549细胞体外侵袭力测定
(每格细胞数185.1±28.1 HE×200)
Fig 1 The assesement of the invasiveness of untreated A549 cells in vitro
(185.1±28.1 cells per lattice HE×200)
, 百拇医药
图2 经IL-1(200 U/ml)处理24 h,A549细胞侵袭力有增强趋势,但差异不显著
(每格细胞数272.6±72.3 HE×200)
Fig 2 IL-1 (200 U/ml) treatment for 24 h increased the invasiveness of A549 cells, but no statistical significance
(272.6±72.3 cells per lattice HE×200)
图3 经IFN α(1 000 U/ml)处理24 h,A549细胞侵袭力降低
(每格细胞数111.4±21.1 HE×200)
, http://www.100md.com
Fig 3 IFN α (1 000 U/ml)treatment for 24 h decreased the invasiveness of A549 cells
(111.4±21.1 cells per lattice HE×200)
图4 经ATRA(5 μmol/L)处理24 h,A549侵袭力降低
(每格细胞数101.2±27.9 HE×200)
Fig 4 ATRA (5 μmol/L) treatment for 24 h decreased the invasiveness of A549 cells (101.2±27.9 cells per lattice HE×200)
, http://www.100md.com
3 讨论
全反维甲酸(ATRA)是体内具有重要生理活性的Vit A代谢产物之一,国内外一些报道表明:RA类化合物具有抑制细胞增殖、诱导肿瘤细胞分化及程序性死亡、抗肿瘤血管生成等特性[3]。我们检测了ATRA、IL-1、IFNα处理的A549细胞体外增殖能力,结果显示:ATRA处理的A549细胞体外增殖明显受抑制,而IFN α、IL-1处理细胞体外增殖无明显变化,与其它报道基本一致。
粘附是肿瘤细胞侵袭转移过程中的重要环节。粘附因子介导肿瘤细胞与细胞外基质、血管内皮细胞、靶器官细胞之间的相互作用,因此与肿瘤侵袭转移行为密切相关[1]。ICAM-1是一种细胞粘附分子,Natali等[5]研究发现ICAM-1表达水平与黑色素瘤瘤体厚度及临床病程有很高的相关性,ICAM-1高表达的肿瘤细胞侵袭转移能力高。我们的实验结果显示:ATRA处理A549细胞后,细胞表面ICAM-1下降,而IL-1处理组ICAM-1表达增强,IFN α处理组ICAM-1表达无明显变化。其他学者[6,7]对黑色素瘤、乳腺癌等的研究,亦发现了相似的结果。这一结果显示,由于IFN α、IL-1和ATRA对肿瘤细胞ICAM-1表达的不同作用可能导致肿瘤细胞侵袭转移行为有所不同,IL-1由于上调肿瘤细胞ICAM-1的表达而增加其侵袭转移的潜能,ATRA下调ICAM-1的表达而抑制其侵袭转移潜能。
, http://www.100md.com
近年来,发现了另一类型的ICAM-1分子,即存在于肿瘤宿主血清或细胞培养上清液中的可溶性ICAM-1(sICAM-1)。sICAM-1的存在,可以阻断LFA-1/ICAM-1介导的淋巴细胞对肿瘤细胞识别,从而抑制机体抗肿瘤免疫,促进转移发生[8]。Parhar等[9]认为nm23基因抗转移能力可能是通过降低肿瘤细胞产生sICAM-1来介导的。从实验结果看:IFN α或ATRA处理A549细胞sICAM-1含量不增高,而IL-1处理细胞后,sICAM-1含量明显增高,由此看ATRA处理细胞使ICAM-1表达降低和sICAM-1含量不增高对抑制肿瘤侵袭转移潜能的作用是一致的。因此,ATRA、IFN α、IL-1对A549细胞体外增殖及ICAM-1、sICAM-1表达有不同的调节作用,而对其转移潜能具有不同调变作用。ATRA对肿瘤的化学预防作用可能是通过抑制细胞增殖、调节2种形式ICAM-1表达进而抑制其转移潜能实现的。
(致谢:感谢附属大坪医院野战外科研究所创伤科简华刚副教授及第二研究室江其生博士对本实验提供的大力协助。)
, 百拇医药
作者简介:周人杰,男,1971.04.05生,浙江省慈溪市人,硕士,住院医师,主要从事肺癌方面的研究,发表论文2篇。电话:(023)68755724
参考文献
[1] Lalani E L N, Laniado M E, Abel P D.Molecular and cellular biology of prostate cancer[J].Cancer Metastasis Rev,1997,16(1):29-66.
[2] Natali P G, Nicotra M R, Cavaliere R, et al.Differential expression of intercellular adhesion molecule 1 in primary and metastatic melanoma lesions[J].Cancer Res,1990,50(15):1271-1278.
, http://www.100md.com
[3] 王志洁.维甲酸化学预防肺癌的研究进展[J].国外医学:肿瘤学分册,1998,25(2):106-109.
[4] Gillies R J, Didier N, Denton M.Determination of cell number in monolayer cultures[J].Anal Biochem,1986,159(1):109-113.
[5] Natali P G, Hamby C V, Felding-Habermann B, et al.Clinical significance of α v β3 integrin and intercellular adhesion molecule-1 expression in cutaneous malignant lesions[J].Cancer Res,1997,57(15):1554-1560.
, 百拇医药
[6] 罗利群,张友会,黄兰青,等.干扰素对小鼠乳腺癌细胞侵袭力及转移相关基因表达的调变[J].中华肿瘤杂志,1997,19(3):184-187.
[7] Creyghton W M, de-Waard-Siebinga I, Danen E H, et al.Cytokine-mediated modulation of integrin ICAM-1 and CD44 expression on human uveal melanoma cells in vitro[J].Melanoma Res,1995,5(4):235-242.
[8] Banks R E, Gearing A J H, Hemingway I K, et al.Circulating intercellular adhesion molecule-1(ICAM-1),E-selectin and vascular cell adhesion molecule-1(VCAM-1)in human malignancies[J].Br J Cancer,1993,68(1):122-124.
[9] Parhar R S, Shi Y,Zou M, et al.Effects of cytokine-mediated modulation of nm23 expression on the invasion and metastatic behavior of B16F10 melanoma cells[J].Int J Cancer,1995,60(2):204-210.
收稿日期:1999-05-05;修回日期:1999-08-10, 百拇医药